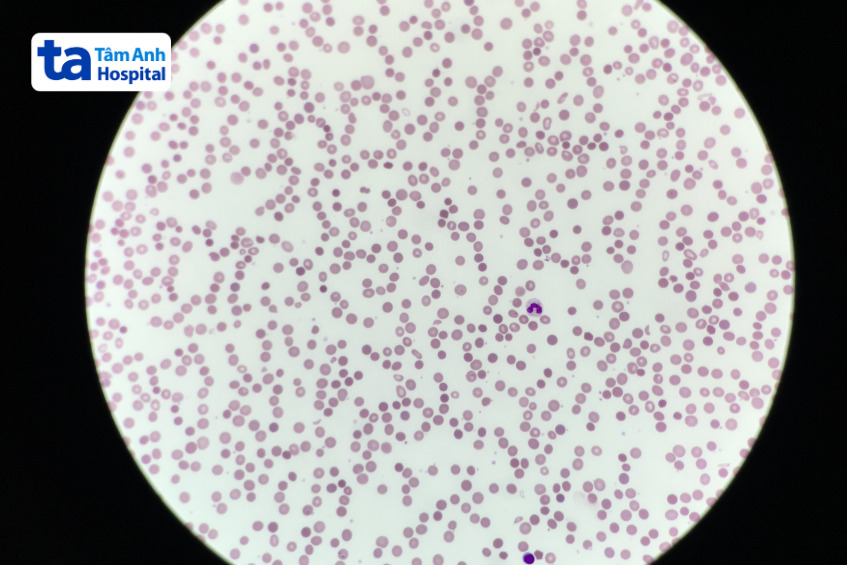
hình ảnh hồng cầu hình cầu

Bệnh hồng cầu hình cầu di truyền (HS) có thể xảy ra ở cả người lớn và trẻ em, ảnh hưởng đến sức khỏe. Vậy bệnh hồng cầu hình cầu là gì? Thiếu máu hồng cầu hình cầu di truyền được chẩn đoán, điều trị thế nào?

Hồng cầu hình cầu là tế bào hồng cầu mất đi hình dạng đĩa đặc trưng, trở thành các tế bào hình tròn hoặc hình cầu (spherocyte). Những hồng cầu bất thường này không thể duy trì hình dạng lõm hai mặt bình thường do đột biến gen ở các protein màng hoặc khung tế bào – có vai trò trong sự ổn định hình thái cấu trúc. Những protein thiếu hụt hoặc bất thường có thể bao gồm ankyrin, spectrin, band 3 và band 4.2, được mã hóa bởi các gen khác nhau. (1)
Bệnh hồng cầu hình cầu di truyền là một rối loạn máu di truyền dẫn đến tình trạng thiếu máu tan máu, xảy ra khi những tế bào hồng cầu bị phân hủy nhanh hơn bình thường. Hồng cầu hình cầu di truyền là nguyên nhân phổ biến dẫn đến thiếu máu tan máu do màng hồng cầu bất thường. (2)
Dựa trên các triệu chứng, dấu hiệu, bệnh hồng cầu hình cầu di truyền thường được phân thành 3 loại nhẹ, trung bình và nặng:
Tất cả người bệnh HS đều bị di truyền do nhận bản sao gen của cha mẹ ruột. Rối loạn di truyền xảy ra khi gen được truyền từ cha mẹ sang con bị đột biến hoặc thay đổi. Trong bệnh hồng cầu hình cầu di truyền, cha mẹ có thể truyền đột biến ở năm gen khác nhau, nhưng gen này cung cấp hướng dẫn cho các protein tạo ra một phần cấu trúc của tế bào hồng cầu. Đột biến gen kể trên cũng quyết định một người bị HS ở dạng nặng hay nhẹ.
Ước tính khoảng 75% người bệnh HS được di truyền theo kiểu trội trên nhiễm sắc thể thường, có nghĩa là chỉ cần một bản sao của gen gây bệnh là có thể gây ra một dạng hồng cầu hình cầu di truyền nào đó. Trẻ em có cha mẹ ruột mang gen đột biến có 50% nguy cơ bị di truyền gen đột biến.
Những người khác bị di truyền bệnh HS do nhận được một bản sao gen đột biến từ mỗi cha mẹ. Đây là một căn bệnh di truyền lặn trên nhiễm sắc thể thường. Ở trường hợp này, cha mẹ là người mang gen bệnh nhưng thường không gặp triệu chứng hoặc dấu hiệu của bệnh HS.
Khi những người mang gen bệnh có con, mỗi đứa trẻ có nguy cơ bị HS khác nhau. Chúng có 25% nguy cơ bị bệnh, 50% nguy cơ mang gen bệnh nhưng không mắc bệnh, 25% cơ hội tránh được việc mang gen bệnh và không mắc bệnh.
Vậy điều điều gì xảy ra khi các gen này đột biến? Tất cả các tế bào đều có màng ngăn cách các thành phần bên trong với môi trường bên ngoài, bảo vệ chúng khỏi môi trường đó. Màng tế bào hồng cầu bao gồm một lớp màng ngoài mỏng. Protein kết nối màng trong với màng ngoài, tạo thành một bộ khung tế bào.
Hồng cầu cần uốn cong, xoắn và xoay để có thể luồn lách qua các mạch máu hẹp, trượt qua lách. Hồng cầu có thể gấp lại chỉ bằng ⅓ kích thước bề mặt của chúng. Màng hồng cầu cho phép hồng cầu giữ nguyên hình dạng đặc trưng của chúng – một đĩa lõm nhưng có thể thay đổi hình dạng khi cần.
Trong bệnh HS, các đột biến gen tác động đến protein màng tế bào hồng cầu, phá vỡ liên kết giữa bộ khung tế bào và lớp ngoài. Liên kết bị vỡ đồng nghĩa với việc bộ khung tế bào không thể hỗ trợ cho lớp ngoài, khiến hồng cầu chuyển từ dạng đĩa mềm dẻo thành dạng cầu cứng, thay vì biến đổi thành các dạng bất thường khác như hồng cầu hình miệng hay hình bầu dục.

Ước tính cứ 2000 – 5000 người trên toàn cầu thì có 1 người bị HS. Các bác sĩ thường chẩn đoán bệnh hồng cầu hình cầu di truyền ở trẻ sơ sinh, trẻ nhỏ. Thế nhưng, một số người bệnh không có triệu chứng, dấu hiệu cho đến 30 – 40 tuổi. Ở nhiều trường hợp, trẻ bị bệnh có triệu chứng trong độ tuổi từ 3 – 8 tuổi. Trong một số trường hợp, để phát hiện bệnh, bác sĩ sẽ chỉ định thực hiện xét nghiệm máu cho trẻ sơ sinh gặp những triệu chứng thiếu máu nặng trong khoảng 1 tuần sau khi sinh.
Hồng cầu hình cầu di truyền dẫn đến thiếu máu tan máu, người bệnh có thể gặp các tình trạng, triệu chứng sau:

Hầu hết người bị HS có tiên lượng tốt, tình trạng bệnh của mỗi người là khác nhau. Tiên lượng phụ thuộc vào các yếu tố như dạng hồng cầu hình cầu di truyền mắc phải, hiệu quả điều trị, những tình trạng bệnh lý khác đồng mắc, sức khỏe tổng thể của người bệnh…
>> Xem thêm: Hồng cầu hình bia bắn: Bất thường nhưng có đáng lo?
Bác sĩ sẽ chẩn đoán tình trạng bệnh HS thông qua việc đánh giá các triệu chứng, tìm hiểu về tiền sử bệnh và chỉ định thực hiện một số xét nghiệm, có thể bao gồm:
Tùy vào triệu chứng, bác sĩ có thể chỉ định áp dụng phương pháp chữa trị phù hợp. Ví dụ, ngay khi bác sĩ chẩn đoán mắc bệnh HS, trẻ sơ sinh bị thiếu máu nghiêm trọng có thể được truyền máu và/hoặc dùng thuốc kích thích hồng cầu (ESA) – một loại thuốc thúc đẩy sản xuất hồng cầu. Một số phương pháp chữa trị tiềm năng khác, gồm:

Người bị bệnh Spherocytosis cần được tái khám định kỳ để bác sĩ có thể kiểm tra tình trạng sức khỏe tổng quát và phát hiện bất kỳ triệu chứng, dấu hiệu mới nào, bao gồm thiếu máu, sỏi mật… Nếu người bệnh cần truyền máu thường xuyên, bác sĩ có thể khuyến nghị tiêm vắc xin phòng ngừa virus viêm gan B.
Bác sĩ có thể đề xuất thực hiện các biện pháp để bảo vệ người bệnh khỏi các bệnh nhiễm trùng do virus, đặc biệt là parvovirus B19, có thể dẫn đến những vấn đề sức khỏe nặng và đột ngột.
Nếu một người có tiền sử gia đình bị HS thì nhiều khả năng không thể phòng ngừa được. Thế nhưng, một người có tiền sử gia đình mắc bệnh HS không nhất thiết là bản thân và/hoặc con cái cũng sẽ mắc bệnh. Nếu lo lắng về tiền sử gia đình, hãy trao đổi với bác sĩ về việc xét nghiệm hồng cầu di truyền.
Bác sĩ sẽ giải thích ý nghĩa của kết quả xét nghiệm, bao gồm cả việc mắc bệnh HS ở mức độ nhẹ, trung bình hay nặng. Từ đó, bác sĩ sẽ có đủ thông tin để xác định các bệnh lý mà người được xét nghiệm nhiều khả năng mắc phải, bao gồm cả các dấu hiệu, triệu chứng ban đầu của bệnh.
HỆ THỐNG BỆNH VIỆN ĐA KHOA TÂM ANH
Tóm lại, hồng cầu hình cầu di truyền là một rối loạn di truyền ít gặp, người bệnh thường cần được điều trị, chăm sóc y tế kéo dài. Ngay khi gặp các dấu hiệu gợi ý bệnh HS, người bệnh cần sớm đến Bệnh viện Đa khoa Tâm Anh hoặc cơ sở y tế uy tín để được bác sĩ thăm khám, chẩn đoán, đề ra phác đồ chữa trị phù hợp.